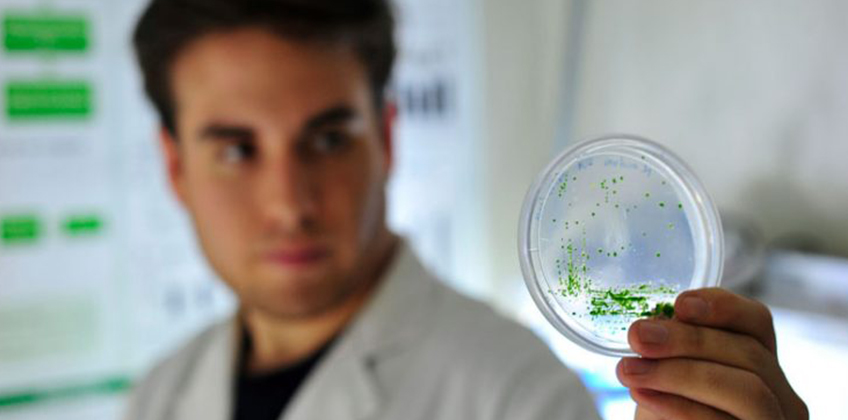
Innovación y vocación regional

A través de sus diez centros temáticos desplegados en el país, la Universidad Santo Tomás ha desarrollado más de 90 proyectos de investigación en respuesta a problemáticas a nivel nacional y local.
Con foco en la generación de conocimiento aplicado en áreas específicas de interés nacional y regional, la Universidad Santo Tomás (UST) —a través de la Vicerrectoría de Investigación y Postgrado—, en los últimos años ha desarrollado acciones concretas mediante la ejecución de proyectos de investigación, la trasferencia de resultados de los mismos y la generación de publicaciones científicas de alto impacto.
Este esfuerzo y dedicación han llevado a la casa de estudios superiores a consolidar su área de investigación, no solo en el mundo académico, sino que también a nivel país. Es así como en 2016 el ranking de universidades del diario La Tercera ubicó a la UST en el séptimo lugar en calidad de la investigación entre 41 instituciones evaluadas.
Vocación regional
Pilar fundamental en este accionar es la labor de los académicos del plantel junto al trabajo de los diez Centros de Investigación Aplicada e Innovación emplazados en distintas ciudades de Chile y cuyo propósito es aportar al desarrollo nacional, en especial en las regiones que es donde existen más necesidades y menos investigadores.
Durante el período 2013-2016, la UST se adjudicó un total de 94 proyectos financiados con fondos externos, entre los que se destacan los financiados por Conicyt; el Fondo de Innovación para la Competitividad (FIC) de distintos gobiernos regionales; y Corfo.
Exequiel González, Vicerrector de Investigación y Postgrado de la UST, señala que la presencia regional de la Universidad “resulta ser una plataforma adecuada para que varios de los centros, sobre todo aquellos cuyos focos de estudio no estén circunscritos a zonas geográficas específicas, comiencen a ejecutar iniciativas con el apoyo y coordinación de distintas sedes de Santo Tomás, con el objeto de incrementar el conocimiento, mejorar procesos productivos y responder adecuadamente a realidades sociales y locales con las cuales la comunidad universitaria se involucra”.
Proyectos destacados de los Centros de Investigación UST
Algunas iniciativas significativas llevadas a cabo durante el último período son “Transferencia sello merino para la ruta textil”, adjudicado por el Centro de Innovación y Desarrollo para los Ovinos del Secano (OVISNOVA); “Fortaleciendo emprendimientos turísticos de mujeres”, del Centro de Investigación y Estudios en la Familia, Trabajo y Ciudadanía (CIELO); y “Modelo piloto de producción y comercialización de algas para consumo humano directo, para la pesca artesanal” del Centro Acuícola Pesquero de Investigación Aplicada de Puerto Montt (CAPIA). A estos, además se suma el proyecto “Desarrollo de técnicas de manejo del recurso Gelidium spp para la diversificación de la producción algal de la Región del Bío Bío”, del Centro de Investigación e Innovación para el Cambio Climático (CiiCC); y la iniciativa del centro Austral Biotech denominada “Inmunoestimulantes para la industria salmonera a partir de cultivos sustentables de microalgas”.
En materia de innovación, el Centro de Investigación y Modelación de Negocios (CIMON) ejecuta proyectos en coordinación con académicos de Santo Tomás entre las sedes Iquique y Concepción. “Actualmente este centro cuenta con una agenda de innovación en alimentos que se coordina desde La Serena, un centro de negocios Sercotec y cowork en el Maule, proyectos con empresas privadas en el Bío-Bío y postulaciones a FIC en Coquimbo y Tarapacá”, explica González.
Nuevos centros
Por otro lado, el plantel educativo en 2016 celebró la puesta en marcha de dos nuevos centros: el de Investigación, Innovación e Inclusión Educativa (CIEDUCA) en Viña del Mar; y el de Investigación e Innovación en Gerontología (CIGAP) en Antofagasta.
Entre sus hitos, también se destaca la creación, en el mismo año, de la Oficina de Transferencia y Licenciamiento (OTL) que está a cargo de la identificación de los resultados del trabajo investigativo de la comunidad académica de la UST, para luego apoyar y promover, tanto la protección de las invenciones, como su aplicación comercial en el entorno social e industrial del país.
- Centros de Investigación Aplicada e Innovación UST
- Centro Acuícola y Pesquero de Investigación Aplicada (CAPIA) www.capia.cl
- Centro de Investigación e Innovación para el Cambio Climático (CIICC) www.ciicc.cL
- Centro de Investigación y Estudios en Familia, Trabajo y Ciudadanía (CIELO) www.centrocielo.cl
- Centro de Innovación y Desarrollo para Ovinos del Secano (OVISNOVA) www.ovisnova.cl
- Centro de Investigación Aplicada en TIC’s para la Educación (TEKIT) www.tekit.cl
- Centro de Investigación y Modelación de Negocios (CIMON) www.cimon.cl
- Centro Austral Biotech www.australbiotech.cl
- Centro Bahía Lomas www.bahialomas.cl
- Centro de Investigación, Innovación e Inclusión Educativa (CIEDUCA) www.cieduca.cl
- Centro de Investigación e Innovación en Gerontología (CIGAP) www.cigap.cl